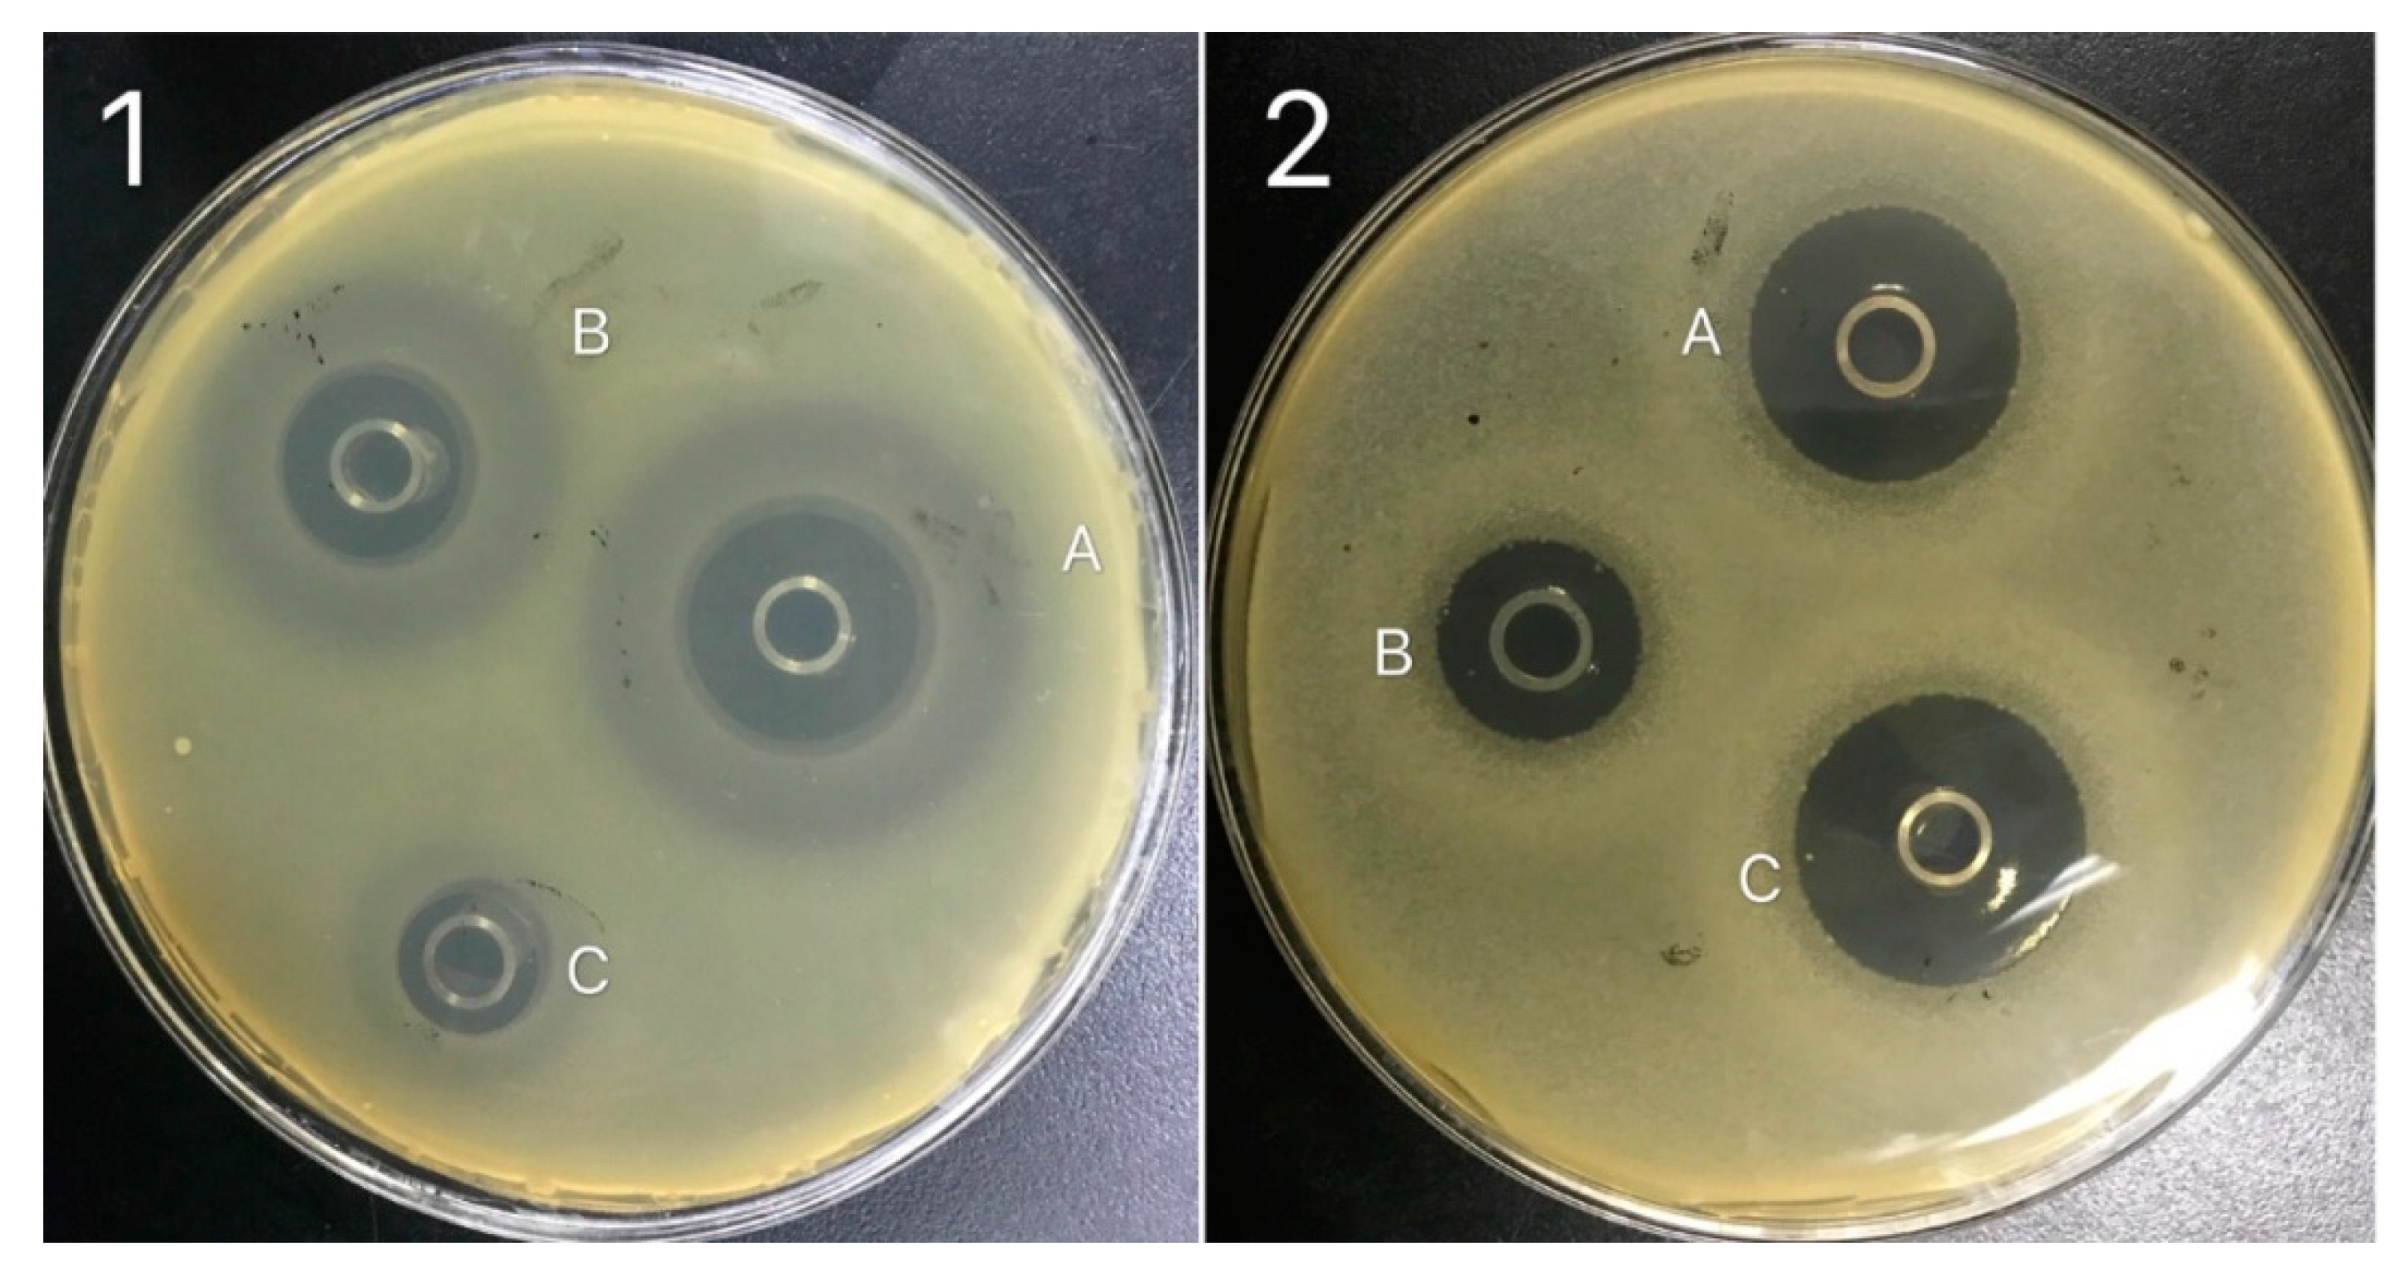
Processes 08 00259 g007

Abstract
Herein, a bactericide-secreting Bacillus strain, potentially useful as a biocontrol agent, was isolated from the commercial Yanjing Natto food. Following the biochemical and physiological evaluation, the molecular identification was performed using 16S rDNA sequencing of polymerase chain reaction-amplified DNA that confirmed the natto isolate as Bacillus subtilis natto (B. subtilis natto). The biocontrol (microbial inhibitory) capability of B. subtilis natto was investigated against Staphylococcus aureus, Escherichia coli, Salmonella typhimurium, and yeast (Yarrowia lipolytica) and recorded. The antimicrobial activity of B. subtilis natto was further enhanced by optimizing the growth medium for optimal bactericides secretion. Under optimized conditions, B. subtilis natto exhibited much higher inhibitory activity against S. aureus with a zone of inhibition diameter up to 27 mm. After 48 h incubation, the optimally yielded B. subtilis natto broth was used to extract and purify the responsible bactericides by silica gel column chromatography, gel column chromatography, and semi-preparative high-performance liquid chromatography. Structural identification of purified bactericides (designated as NT-5, NT-6, and NT-7) from B. subtilis natto was performed by 13C-nuclear magnetic resonance (NMR) and mass spectral analyses. The NMR comparison also revealed that NT-5, NT-6, and NT-7 had identical structures, except for the fatty chain. In summary, the present study suggests the improved biocontrol and/or microbial inhibitory potential of newly isolated bactericides secreting B. subtilis natto.
1. Introduction
Natto as a traditional food with a history of two thousand years has various healthcare functions such as prevention of osteoporosis, procoagulant, antimicrobial, anti-aging, anti-cancer, and gastrointestinal activities [1,2,3]. Bacillus subtilis natto (B. subtilis natto) is an aerobic Gram-positive probiotic that possesses a strong heat and acid-base stability [4]. This edible strain is claimed to be the organism primarily responsible for natto fermentation. It has a variety of functions including promoting the absorption of iron, calcium, and vitamin D by generating intestinal acidification [5]. B. subtilis natto metabolites also have antihypertensive, anti-tumor, anti-oxidation, thrombolytic and other functions. Among all these properties, potent antibacterial activity is one of the most important functions of B. subtilis natto and might be due to the production of bacitracin, polymyxin, 2,6-pyridine dicarboxylic acid, and other antibiotics. It has the role of inhibiting pathogens such as Salmonella typhimurium and dysentery bacteria. Along with a broad antimicrobial spectrum, B. subtilis natto-derived antimicrobial substances are safe for humans as compared to other drugs [3,6,7].
A pronounced antibacterial activity against Helicobacter pylori has been found in B. subtilis natto cells. Through the minimum inhibitory concentration (MIC) tests, it was confirmed that B. subtilis natto possessed anti-platelet aggregation and anti-H. pylori activity due to the presence of dipicolinic acid [8]. Based on morphological studies, a bacterial isolate BH072 from a honey sample exhibited a broad-spectrum inhibitory activity against a range of molds including Aspergillus niger, Botrytis cinerea, and Pythium [9]. A lipopeptide biosurfactant was purified from B. natto TK-1 by acidic precipitation, methanol extraction, and thin-layer chromatography (TLC) system, and its in-vitro anti-adhesion activity was investigated. Results indicated that lipopeptide presented noteworthy antimicrobial properties and significantly inhibited the adhesion of Escherichia coli, Staphylococcus aureus, and S. typhimurium [3]. Vibrio parahaemolyticus is an emerging foodborne pathogen in seafood products. Effective measures to prevent V. parahaemolyticus in seafood would help minimize the probability of foodborne illness and large outbreaks of Vibrio. B. subtilis NT-6 isolated from natto secretes a novel antibacterial peptide AMPNT-6 that is a potent inhibitor of V. parahaemolyticus (up to 15.5 mm diameter). These results manifested that AMPNT-6 might be potentially employed as a natural inhibitor of V. parahaemolyticus on shrimp substrates [10].
Due to increasing people’s health requirements, food safety standards have become more stringent, and considerable attention has been focused on food preservatives. Low-cost natural and broad-spectrum food preservatives are an emerging trend around the world. Compared with chemical preservatives, food preservatives produced using traditional fermented foods are newer, safer and more effective. Antibacterial substances in natto not only have the advantages of high safety, broad antibacterial spectrum but also rich in nutrition and functionality [11,12]. Nevertheless, there are few reports on the antibacterial activity of B. subtilis natto. Moreover, the main components and structure of the antibacterial substances are still unclear, and the antibacterial ability is weak. This study aims to isolate and purify the bactericides secreting B. subtilis natto. The biocontrol capability of B. subtilis natto was also evaluated against E. coli, S. aureus, S. typhimurium, and yeast (Y. lipolytica). Moreover, advanced instrumental techniques were used to elucidate the structural features of bactericides extracted from B. subtilis natto. The research of antibacterial baring compounds extraction and purification promoted its application in medicines and preservatives and expected to develop into new antibacterial drugs.
2. Materials and Methods
2.1. Materials, Chemicals, and Reagents
The natto food was obtained from Beijing Yanjing Zhongwu Material Technology Co., Ltd. (Beijing, China). Ethylenediaminetetraacetic acid (EDTA), glucose, cornflour, sucrose, soluble starch, soy flour, NaCl, tryptone, beef cream, ammonium nitrate, ZnSO4, FeSO4, and K2SO4 were purchased from Sinopharm Chemical Reagent Co., Ltd. (Shanghai, China). Shanghai Aladdin Biochemical Technology Co., Ltd. (Shanghai, China) provided n-hexane, ethyl acetate, methylene dichloride, and methanol. All aqueous solutions were prepared with deionized water. All other chemicals/reagents used in this study were the highest quality and used as received without any further processing unless otherwise stated.
2.2. Microbial Strains
Escherichia coli, S. aureus, S. typhimurium, and Y. lipolytica were procured from Shanghai Luwei Microbial Science and Technology Co. Ltd. (Shanghai, China). B. subtilis natto strain was isolated from natto food. All collected and isolated microbial cultures were maintained on nutrient agar slopes at 37 °C for 24 h. After the stipulated period of 24 h incubation, the viable cultures were preserved at 4 °C and sub-cultured periodically every two weeks to maintain the viability.
2.3. Isolation and Screening of B. subtilis Natto
As received natto was washed twice with warm water to eliminate the dust particles. One-gram natto was soaked in 10 mL sterile saline solution and heated in a water bath at 80 °C for 1.0 h. The natto mixture with the elimination of solid matters was allowed to cool at room temperature (25 ± 3 °C) and used as a bacterial suspension. The bacterial suspension was then serially diluted from 10−1 to 10−9 to reduce the concentration of microorganisms and spread on a sterile agar plate containing 20 mL of solidified screening medium. The freshly inoculated plates were placed at 37 °C for a time of 24 h. The resulting bacterial colonies were further purified by streaking on a screening medium, Gram-stained and observed under an optical microscope using the oil-immersion lens. A single bacterial colony was further subjected to a series of physiological and biochemical identification tests. Following Bergey’s Manual of Determinative Bacteriology, catalase test, starch hydrolysis, salt tolerance (i.e., 2%, 5%, 7%, and 10%), gelatin liquefaction, acetyl methyl, Voges-Proskauer (VP), D-glucose and D-mannitol fermentation, and nitrate reduction were performed.
2.4. Molecular Identification: DNA Extraction and PCR Amplification
A bacterial genomic DNA extraction kit (EasyTaq® DNA Polymerase, Transgen Biotech, Beijing, China) was used for molecular identification purposes. Briefly, an overnight grown B. subtilis natto was centrifuged at 4000× g for 10 min. The extracted DNA was used as a template for polymerase chain reaction (PCR) to amplify about 500 or 1500 bp segment of the 16S rRNA gene sequence using the universal primers 27F (5′-AGAGTTTGTCCTGGCTCAG-3′), 1492R (5′-TACGGCTACCTT GTTACGACTT-3′). PCR amplification system (50 μL) contains; 1 μL genomic DNA, 1 μL each of upstream and downstream primers, 1 μL EasyTaq DNA Polymerase, 4 μL High pure dNTPs (EasyPure Genomic DNA Kit, Transgen Biotech), 5 μL 10× EasyTaq Buffer and ddH2O. The amplification was performed in a thermal cycler (Thermo Fisher Scientific, Waltham, MA, USA) by DNA denaturation at 94 °C for 3 min followed by 30 cycles of 30 s at 94 °C, 30 s at 55 °C (Tm), and 30 s at 72 °C and an ultimate extension of 5–10 min at 72 °C.
2.5. S rDNA Sequencing and Data Analysis
Samples were prepared and sequenced by the Shanghai Bioengineering Co., Ltd. China accredited laboratory. The target gel band was purified using the TaKaRa MiniBEST Purification Kit. The sequences obtained with the 1492R primer were aligned and compared with other partial 16S rDNA sequences in the GenBank database (http://www.ncbi.nlm.nih.gov/BLAST). The obtained 16S rDNA sequence was deposited to GenBank for assigning accession numbers by NCBI.
2.6. Microbial Cultural Conditions
B. subtilis natto strain was cultivated in seed culture medium (pH 7.2–7.4) containing peptone 10 g/L; beef extract 5 g/L, NaCl 6 g/L, and glucose 5 g/L at 37 °C for 24 h. The screening medium includes skim milk powder 50 g/L, NaCl 5 g/L, glucose 10 g/L, agar 20 g/L. The medium was sterilized in a laboratory-scale autoclave at 115 °C and 15 psi for 30 min. The agar medium contained 0.1 MPa and water addition and sterilized at 121 °C for 15 min. After cooling slightly, both were uniformly mixed. Constant temperature and humidity culture at 37 °C for 24 h. The fermentation medium comprises peptone 5 g/L, sodium chloride 5 g/L, glucose 20 g/L, KH2PO4 2 g/L, and K2HPO2 4 g/L. The medium was sterilized at 115 °C for 30 min. The culture was incubated at 37 °C at 150 rpm. Potato dextrose agar (PDA) containing potato 200 g/L, glucose 20 g/L and agar 15~20 g/L was used for the cultivation of yeast. Whereas medium comprised of tryptone 10 g/L, yeast extract 5 g/L, and NaCl 10 g/L was used for S. typhimurium cultivation.
2.7. Antimicrobial Activity of B. subtilis Natto Extract
B. subtilis natto has a unique potential to secrete bactericidal compounds of high interest. For such reason, a cell-free extract of freshly grown B. subtilis natto was used to test the inhibitory activity towards E. coli, S. aureus, S. typhimurium, and yeast. Briefly, around 100 mL liquid seed medium was inoculated with a 5% of freshly grown B. subtilis natto inoculum suspension. The inoculated seed medium was incubated at 37 °C for up to 48 h under uninterrupted shaking at 160 rpm. After 48 h incubation, the fermented broth was centrifuged at 4000× g for 15 min, and the cell-free supernatant was further filtered through a 0.45 μm polysulphonate membrane filter. The resulting filtered cell-free supernatant was considered as a bactericidal containing crude extract and tested using the agar well diffusion assay against selected strains. Briefly, sterilized discs were gently placed onto the center of the agar plate with sterile forceps following the addition of 20 μL of bactericidal containing cell-free supernatant to the discs. The inhibition zone diameter (mm) formed around the disks was recorded after the plate’s incubation at 37 °C for 24 h [13]. Kanamycin at the concentration of 30 μg/mL, and water ware used as a positive and negative control, respectively.
2.8. Minimal Inhibitory Concentration of B. subtilis Natto against Pathogenic Bacteria
The broth dilution method, in test tubes, was adopted to record the minimum inhibitory concentration (MIC) of pathogenic bacteria, according to the procedure described earlier [14,15,16] with some modifications. Briefly, different extract preparations were serially diluted using sterile nutrient broth medium as a diluent to prepare a final crude extract concentration between 0.578 and 2400 μg/mL. All the tubes were inoculated with the bacterial suspension (adjusted to 107 CFU/mL broth), mixed and incubated for 24 h at 37 °C. The lowest concentration of B. subtilis natto (highest dilution), displaying no noticeable growth of pathogenic bacteria was defined as MIC. A tube with an equal volume of water was used as a control in parallel to evaluate the influence of the sterile medium on the growth of the test bacteria.
2.9. Optimization of Growth Medium to Induce the Antibacterial Activity of B. subtilis Natto
The types of carbon, nitrogen and inorganic salts in the fermentation medium also have a certain influence on the metabolism of the bacteria. Therefore, in this experiment, different carbon sources (2.0% corn flour, glucose, sucrose, and soluble starch), nitrogen source (0.5% soy flour, tryptone, beef extract, ammonium nitrate, and inorganic salts (0.5% potassium dihydrogen phosphate, zinc sulfate, ferrous sulfate, potassium sulfate) were screened and optimized by a single factor optimization. The size of the inhibition zone was measured after 48 h of culture.
2.10. Extraction and Purification of Bactericides from B. subtilis Natto
According to the results of orthogonal experiments, B. subtilis natto was aerobically grown in an Erlenmeyer flask (250-mL capacity) containing sucrose 1%, soy flour 0.8%, potassium sulfate 0.2%, sodium chloride 0.5%, and water 1 L under optimized culture conditions at 37 °C for 36 h on a rotary shaker (120 rpm). After cultivation, the fermentation broth was harvested by centrifugation at 4000× g and 4 °C for 20 min. The fermentation broth was added with ethyl acetate in a ratio of 1:1, thoroughly mixed, and allowed to stand in a separating funnel for two h. The extract was collected and concentrated using a rotary evaporator. The resulting brown extract (10.1 g) was purified by silica gel vacuum liquid chromatography using a 20 × 8 cm column eluted with gradient solvents of increasing polarity (n-hexane−EtOAc, 9:1, 7:3, 1:1, 3:7; CH2Cl2−MeOH, 15:1, 9:1, 7:3, 0:10; 600 mL each gradient) yielding a total of three fractions. Fractions A-4 and A-5 exhibiting antibacterial activity against E. coli and S. aureus were chosen for additional separation. Fraction A-4 (280.7 mg) and A-5 were passed through a Sephadex LH-20 column (60 × 3 cm) using methanol as a mobile phase to remove pigments, and then purified by a semi-preparative high-performance liquid chromatography (Eurospher C18 column) giving NT-5 (15.3 mg), NT-6 (45.5 mg) and NT-7 (51 mg) (MeOH−H2O: 0 min, 20%; 2 min: 30%; 7 min: 50%; 10 min-15 min: 100%).
2.11. Structural Identification of Bactericides from B. subtilis Natto
The samples were dissolved in 2% C5D5N or CDCl3. 13C-NMR spectra were obtained at 150 MHz on a Bruker Avance III NMR spectrometer (Bremen, Germany). HRESIMS (High-resolution electrospray ionization mass spectrometry) data were obtained from an ultra-high-resolution quadrupole time-of-flight (UHR-qTOF) Maxis 4G mass spectrometer (Bruker Daltonics, Bremen, Germany).
3. Results and Discussion
3.1. Isolation and Purification of B. subtilis Natto
For initial isolate screening, Gram staining was performed on a 24 h B. subtilis natto culture incubated at 37 °C under uninterrupted shaking (150-rpm) using LB liquid medium. According to the characteristics of protease secreted by Bacillus natto, protease-producing Bacillus was isolated using a milk culture medium (Figure 1A). The Gram-stained isolate was then subjected to a microscopic observation that revealed following characteristics, Gram+, rod-like in shape, flagella to form buds (full or sub-elastic), and elliptical with no obvious swelling (Figure 1B). After that, the second screening was performed covering various physiological and biochemical parameters and the results obtained are listed in Table 1. Based on the recorded characteristics during the first and second screening, the isolate was assumed to be Bacillus subtilis natto, which was further subjected to a molecular identification via agarose gel electrophoresis and 16S rDNA sequencing data analysis.
Figure 1.
(A) Milk screening medium at 37 °C for 48 h; (B) Microscopic morphology of bacterial isolate cultured in LB liquid medium at 37 °C, 150 rpm for 24 h.
Table 1.
Physiological and biochemical identification tests to identify B. subtilis natto.
3.2. Molecular Identification: 16S Ribosomal DNA Sequence Analysis
The molecular identification of bacterial isolate from natto food was carried out based on 16S rDNA sequencing data analysis. The 16S rDNA sequence of the amplified PCR product was found to be about 1500 bp long. Comparative analysis of the 16S rDNA nucleotide sequence from the newly isolated strain with the GenBank database sequences showed 99% similarity with the equivalent sequences from the species B. subtilis. According to the Berger’s Bacterial Identification Manual and 16s rRNA results, the bacterium is B. subtilis natto.
3.3. Antibacterial Activity of B. subtilis Natto
The antibacterial activity spectrum of B. subtilis natto was evaluated based on the extent of growth-inhibiting potential of four microbes, i.e., S. aureus, E. coli, S. typhimurium, and yeast by direct antagonism on agar plates using a two-layer plate method. Results revealed that B. subtilis natto has significant inhibitory activity against S. aureus and E. coli (Figure 2). Whereas, the antibacterial activity against S. typhimurium was observed to be very weak, and there was almost no inhibitory activity on yeast (Figure 2). In addition, MIC test results showed that the MIC value of B. subtilis natto against E. coli was 6.1 μg/mL, and the MIC value against S. aureus was 8.9 μg/mL.
Figure 2.
Inhibition zone of pathogenic bacteria, (A) Staphylococcus aureus, (B) Escherichia coli, (C) Yeast, (D) Salmonella typhimurium (E) Water, and (F) Kanamycin.
3.4. Optimization of Growth Medium to Induce the Antibacterial Activity of B. subtilis Natto
A classical optimization method (one factor at a time) was performed to induce the growth of B. subtilis natto for optimum performance. For such reason, the influence of various carbon sources, nitrogen sources and inorganic salt on the growth of bactericide secreting B. subtilis natto was evaluated, and the results obtained are shown in Figure 3A–C. Among different carbon sources, sucrose had the greatest effect on the antibacterial activity of B. subtilis natto (inhibition zone, 21.1 mm) followed by soluble starch, D-glucose and corn flour (Figure 3A). Similarly, the addition of ammonium nitrate and potassium dihydrogen phosphate showed a profound inhibitory effect with a diameter zone of 23.0 mm and 20.1 mm among the nitrogen sources (Figure 3B) and inorganic salts (Figure 3C), respectively. Based on the single factor screening results, ammonium nitrate (nitrogen source) had the greatest influence on the antimicrobial activity of different pathogenic strains, followed by sucrose (carbon source) and KH2PO4 (inorganic salt) (Figure 3C). Therefore, these selected factors were further optimized using three levels for each factor in nine experimental runs designed according to the Taguchi’s orthogonal method (orthogonal layout L9). The three variables and their respective levels (coded as 1, 2, 3) are listed in Table 2. Response results in terms of the inhibition zone diameter of all these different combinations of the three factors were appraised using the analysis of variance (ANOVA). Scores (response results) are summed up for each factor and each level (k 1, k 2 and k 3 for levels 1, 2 and 3, respectively) as well as averaged (K 1, K 2 and K3 for levels 1, 2 and 3, respectively). It can be observed from the orthogonal array experiment that the inhibition zone reached 27 mm under the optimized medium combination of experiment 6 (Table 3). The optimization scheme was AB3C1 indicating that sucrose 1%, 2%, 3% can be used, whereas soy flour 0.8%, and potassium sulfate 0.2% showed the best antibacterial effect. Notably, the bacteriostatic effect was significantly improved after the optimization of medium components. Most of the previous reports have shown that B. natto has the ability to inhibit E. coli and S. aureus, but its antibacterial activity was found to be very weak. Through the optimization of the medium, B. subtilis natto exhibited a potent inhibitory activity towards S. aureus with an antibacterial diameter of up to 27 mm (Figure 4, Table 3). Earlier studies have mainly focused on the antifungal or antitumor activity of B. natto, and there are few reports on inhibition of S. aureus and E. coli.
Figure 3.
Effects of different (A) carbon sources (B) nitrogen sources and (C) inorganic salts on the antibacterial potential of B. subtilis natto.
Table 2.
Factors and their respective assigned levels.
Table 3.
Results of the L9 (3 × 3) orthogonal array experiment.
Figure 4.
The optimal medium of fermentation broth against the inhibition zone diameter of Staphylococcus aureus.
3.5. Purification of Bactericides from B. subtilis Natto
The fermentation broth obtained from B. subtilis natto under optimized cultivation conditions was harvested by centrifugation at 4000× g and 4 °C for 15 min. The resultant cell-free supernatant was mixed with ethyl acetate and subjected to the rotary evaporator to obtain a concentrated extract. The resulting extract was subjected to silica gel vacuum liquid chromatography, which yielded three fractions. Among these, fractions A-4 and A-5 presenting inhibitory activity towards E. coli and S. aureus were further separated using a Sephadex LH-20 column to remove pigments and then purified by a semi-preparative HPLC into three fractions designating as NT-5, NT-6, and NT-7 (Figure 5). As evident from the HPLC pattern, the fractions NT-5, NT-6 and NT-7 were 100% purified with the retention time of 30.613, 35.583 and 36.067 min, respectively.

Figure 5.
HPLC patterns; (A) NT-5, (B) NT-6 and (C) NT-7.
3.6. Structural Elucidation by 13C-NMR and Mass Spectral Analyses
The structural elucidation of purified bactericides designated as NT-5, NT-6 and NT-7 were further confirmed by 13C NMR analysis at 150 MHz. 13C-NMR displayed different peaks for each tested fraction, which are summarized in Table 4. Compound NT-5 eluting at 30.613 min in the HPLC analysis displayed a protonated molecular ion [M+H]+ at m/z 1008.6 (Figure 6A). Compound NT-6 eluting at 35.583 min in the HPLC analysis showed a protonated molecular ion [M + H]+ at m/z 1022.5 (Figure 6B). Compound NT-7 eluting at 36.067 min in the HPLC analysis and revealed a protonated molecular ion [M + H]+ at m/z 1036.8 (Figure 6C). The NMR data of NT-5, NT-6, and NT-7 summarized in Table 4 were consistent with the literature [17] and verified that NT-5, NT-6, and NT-7 has an inhibitory effect on E. coli and Staphylococcus aureus (Figure 7). The proposed structures of three active compounds are portrayed in Figure 8.
Table 4.
13C-NMR data for NT-5, NT-6, and NT-7 fractions.

Figure 6.
Mass spectral analyses (A) NT-5, (B) NT-6 and (C) NT-7.
Figure 7.
Inhibition zone of pathogenic bacteria, (1) Staphylococcus aureus, (2) Escherichia coli. (A) NT-5, (B) NT-6 and (C) NT-7.
Figure 8.
Proposed structures of three active compounds.
Antagonism is omnipresent in Nature among diverse species. People have remained interested for a long time in realistically using it in the areas of agricultural defense, disease therapy, and food preservation. Bacterial reproduction is challenging to control and can cause massive food losses. Extensive use of food additives is another serious problem that may cause harm to people’s bodies. Using a biological antibacterial agent to control bacterial diseases is a widespread theme that has been widely investigated [18,19,20,21,22,23,24]. In contrast to chemical biocides, numerous antibiotics produced by antagonistic strains present the advantage of being decomposable leaving no detrimental residues. The rapid emergence of resistant pathogenic strains and the identification of adverse chemical moieties in the food chain has rekindled the researcher’s attention towards green approaches to effectively tackling pathogenic bacteria. Among the alternatives, biological control by means of natural antagonistic microorganisms has been widely deliberated, and some Bacillus strains are effective against various microbial pathogens under the optimal medium composition [3,9,20]. For example, Tabbene et al. [25] found that nutrients such as carbon, nitrogen sources, and inorganic salts enhanced the antimicrobial activity by B. subtilis B38 against pathogenic Salmonella enteridis, Listeria monocytogenes, and methicillin-resistant Staphylococcus species. In comparison to basal medium, the antibacterial activity was 2- to 4-fold improved in the modified culture medium consisting of 0.15% (w/v) ammonium succinate, 1.5% (w/v) lactose, and 0.3 mg/L manganese. The results indicate that the nutrients act as environmental factors, qualitatively and quantitatively influencing the synthesis of antimicrobial compounds by B. subtilis B38.
Antimicrobial peptides secreted by Bacillus spp. have been demonstrated as potent biocontrol candidates against a plethora of phytopathogens [26,27]. This study isolated and identified a strain that has shown significant inhibitory activity against various bacterial strains, and also has shown potential for the synthesis of antimicrobial agents. A novel antibacterial peptide, AMPNT-6, secreted by B. subtilis NT-6 showed an evident inhibitory activity against Vibrio parahaemolyticus with a diameter and MIC of 15.5 mm and 1.25 mg/mL, respectively. In comparison to the control, the significant bactericidal activity through the changes of V. parahaemolyticus growth curve indicate that AMPNT-6 can potentially be used as a natural inhibitor to reduce the likelihood of foodborne outbreaks of Vibrio [10]. Wang et al. [28] isolated a B. subtilis natto CSUF5 strain and its antifungal metabolites were extracted from the medium of the inhibition zone on the dual culture plate. The identified V7-surfactins and I/L7-surfactins exhibited slight antifungal activities against Aspergillus Niger, and their MIC50 reduced in the order V7 > I/L7. Microscopic analysis revealed that surfactin variants delayed the fungal spore germination and thus suppressed the hyphae growth, mainly displayed in hyphal shriveling and distortion [28]. Surfactin is a biosurfactant produced by B. subtilis was first observed in 1968 in a culture broth of B. subtilis and was initially purified as a fibrin-clotting inhibitor. It is one of the most effective and potent lipopeptide-type biosurfactants produced by different Gram-positive and endospore-producing B. subtilis strains [28,29,30]. It is a cyclic lipopeptide characterized by a 9-hydroxycarbonic acid moiety with profound surface activities as well as antibiotic activity [31]. Cyclic lipopeptides including fengycin, iturin, lichenysin, and surfactin are among the major categories of biosurfactants secreted by Bacillus species [32]. Biosurfactants from Bacillus strains have been reported to exhibit profound antibacterial and antifungal activities, and the antimicrobial activity was increased with increasing concentration of biosurfactants. A lipopeptide biosurfactant produced by B. natto TK-1 showed strong antimicrobial activity against Botrytis cinerea, Fusarium moniliforme, Micrococcus luteus and S. typhimurium. The biosurfactant also significantly reduced the tumor cell viability in a dose-responsive manner [3]. Various lipopeptide biosurfactants secreted by B. licheniformis [33,34] and B. subtilis [35,36] have also revealed antimicrobial activities. For instance, antimicrobial activities of surfactin and iturin produced by Bacillus strains to inhibit phytopathogenic fungi have been described [34,37,38]. Standard surfactin, which was originally purified from B. subtilis, contained macrolide with the heptapeptide sequenced Glu-Leu-Leu-Val-Asp-Leu-Leu and a lipid fraction that consists of a mixture of several hydroxy-fatty acids (chain length of 13-15 carbon atoms) [39]. Taken together, the present results revealed that the lipopeptide surfactants produced by the Bacillus genus display a high perspective for biopharmaceutical and biotechnological applications owing to their biocontrol activities.
4. Conclusions
In conclusion, a Gram+ bacterial strain isolated from the commercially available natto and identified as B. subtilis natto has considerable inhibitory properties against S. aureus, E. coli, and S. typhimurium. The bactericide’s secretion potential of B. subtilis natto was further optimized via the classical approach under different growth conditions. Through the optimization of the growth medium, its bacteriostatic performance was reaffirmed and found the highest against S. aureus. The previous reports have shown that B. subtilis natto can inhibit E. coli and S. aureus, but its antibacterial potential is weak. However, herein, we have eliminated this limited/weak activity drawback, and under-optimized environment, B. subtilis natto exhibited much higher inhibitory activity towards S. aureus with a zone of inhibition diameter up to 27 mm. The fermentation broth of B. subtilis natto was purified via silica gel and Sephadex column chromatography to extract bactericide baring active compounds and designated as NT-5, NT-6, and NT-7. HPLC, MS, and 13C-NMR further analyzed the active compound fractions to elucidate their structural features. Comparison of the NMR data of NT-5, NT-6, and NT-7 indicated that they share the same structure except for the fatty chain. Future studies are ongoing in our lab to scrutinize the exact chemical structure and cellular toxicity of these compounds as potential candidates for biomedical purposes.
Author Contributions
Conceptualization, J.Z. (Jing Zhang) and Y.Z.; Data curation, J.Z. (Jing Zhang), H.L. (Hedong Lu), and H.S.; Formal analysis, J.Z. (Jiaheng Zhang) and S.L.; Investigation, H.L. (Hongzhen Luo); Methodology, M.B.; Project administration, Y.Z.; Supervision, Y.Z.; Validation, C.L.; Writing—original draft, M.B., H.M.N.I., and Y.Z.; Writing—review & editing, M.B., H.M.N.I., and Y.Z. All authors have read and agreed to the published version of the manuscript.
Funding
This work was financially supported by Young academic leaders in Jiangsu Province, Six talent peaks project in Jiangsu Province (2015-SWYY-026). The authors also acknowledge the support from the Postgraduate Research & Practice Innovation Program of Jiangsu Province (SJCX17_0700), a study on highly efficient biotransformation of oleic acid and linoleic acid to γ-decalactone in Yarrowia lipolytica based on synthetic biology (21606097), Huai’an Agricultural and Social Development Project (HAN201812), and Huai’an Special Fund Project for the Transformation of Scientific and technological achievements (HA201803). We would also like to express sincere appreciation to Professor Peter Proksch (Institute of Pharmaceutical Biology and Biotechnology, Heinrich-Heine-Universität Düsseldorf, 40225 Düsseldorf, Germany) for his assistance during the experiment.
Conflicts of Interest
The authors declare no conflict of interest.
References
- Tsukamoto, Y.; Ichise, H.; Kakuda, H.; Yamaguchi, M. Intake of fermented soybean (natto) increases circulating vitamin K 2 (menaquinone-7) and γ-carboxylated osteocalcin concentration in normal individuals. J. Bone Miner. Metab. 2000, 18, 216–222. [Google Scholar] [CrossRef]
- Ju, H.K.; Jun, P.Y.; Lei, Z.; Yi, P.Q. Identification of two novel fibrinolytic enzymes from Bacillus subtilis QK02. Comparative. Biochem. Physio. Part C 2004, 137, 65–74. [Google Scholar]
- Cao, X.-H.; Liao, Z.-Y.; Wang, C.; Yang, W.-Y.; Lu, M.-F. Evaluation of a lipopeptide biosurfactant from Bacillus natto TK-1 as a potential source of anti-adhesive, antimicrobial and antitumor activities. Braz. J. Microbiol. 2009, 40, 373–379. [Google Scholar] [CrossRef]
- Sumi, H.; Hamada, H.; Nakanishi, K.; Hiratani, H. Enhancement of the Fibrinolytic Activity in Plasma by Oral Administration of Nattokinases. Acta Haematol. 1990, 84, 139–143. [Google Scholar] [CrossRef]
- Tam, N.K.M.; Uyen, N.Q.; Hong, H.A.; Duc, L.H.; Hoa, T.T.; Serra, C.; Henriques, A.; Cutting, S. The Intestinal Life Cycle of Bacillus subtilis and Close Relatives. J. Bacteriol. 2006, 188, 2692–2700. [Google Scholar] [CrossRef]
- Tomohiro, H.; Rieko, H.; Shizue, S.; Akio, A.; Kan, K.; Shuichi, K. Cytokine responses of human intestinal epithelial-like Caco- 2 cells to the nonpathogenic bacterium Bacillus subtilis (natto). Inter. J. Food. Microbiol. 2003, 82, 255–264. [Google Scholar]
- Itaya, M.; Nagasaku, M.; Shimada, T.; Ohtani, N.; Shiwa, Y.; Yoshikawa, H.; Kaneko, S.; Tomita, M.; Sato, M. Stable and efficient delivery of DNA toBacillus subtilis(natto) using pLS20 conjugational transfer plasmids. FEMS Microbiol. Lett. 2019, 366, 032. [Google Scholar] [CrossRef] [PubMed]
- Sumi, H.; Ohsugi, T.; Ikeda, S.; Kawahara, T.; Naito, S.; Yatagai, C. ID: 101 Anti-platelet aggregation and anti-Helicobacter pylori activity of dipicolinic acid contained in Bacillus subtilis natto. J. Thromb. Haemost. 2006, 4, 217. [Google Scholar] [CrossRef]
- Zhao, X.; Zhou, Z.-J.; Han, Y.; Wang, Z.-Z.; Fan, J.; Xiao, H.-Z. Isolation and identification of antifungal peptides from Bacillus BH072, a novel bacterium isolated from honey. Microbiol. Res. 2013, 168, 598–606. [Google Scholar] [CrossRef]
- Xu, D.; Wang, Y.; Sun, L.; Liu, H.; Li, J. Inhibitory activity of a novel antibacterial peptide AMPNT-6 from Bacillus subtilis against Vibrio parahaemolyticus in shrimp. Food Control. 2013, 30, 58–61. [Google Scholar] [CrossRef]
- Mo, H.; Zhu, Y.; Chen, Z. Microbial fermented tea—A potential source of natural food preservatives. Trends Food Sci. Technol. 2008, 19, 124–130. [Google Scholar] [CrossRef]
- Schmidt, S.E.; Taylor, T.M.; Davidson, P.M. Chemical Preservatives and Natural Antimicrobial Compounds. Food Microbiol. 2013, 765–801. [Google Scholar]
- Goñi, P.; López, P.; Sanchez, C.; Gómez-Lus, R.; Becerril, R.; Nerín, C. Antimicrobial activity in the vapour phase of a combination of cinnamon and clove essential oils. Food Chem. 2009, 116, 982–989. [Google Scholar] [CrossRef]
- Andrews, J.M. Determination of minimum inhibitory concentrations. J. Antimicrob. Chemother. 2001, 48, 5–16. [Google Scholar] [CrossRef]
- Fazeli, M.R.; Amin, G.R.; Ahmadian-Attari, M.M.; Ashtiani, H.; Jamalifar, H.; Samadi, N. Antimicrobial activities of Iranian sumac and avishan-e shirazi (Zataria multiflora) against some food-borne bacteria. Food Control. 2007, 18, 646–649. [Google Scholar] [CrossRef]
- Vaquero, M.R.; Alberto, M.; De Nadra, M.C.M. Antibacterial effect of phenolic compounds from different wines. Food Control. 2007, 18, 93–101. [Google Scholar] [CrossRef]
- Pang, X.; Zhao, J.; Fang, X.; Liu, H.; Zhang, Y.; Cen, S.; Yu, L. Surfactin derivatives from Micromonospora sp. CPCC 202787 and their anti-HIV activities. J. Antibiot. 2016, 70, 105–108. [Google Scholar] [CrossRef]
- Raaijmakers, J.M.; Vlami, M.; De Souza, J.T. Antibiotic production by bacterial biocontrol agents. Antonie Leeuwenhoek 2002, 81, 537–547. [Google Scholar] [CrossRef]
- Asthana, R.K.; Deepali; Tripathi, M.K.; Srivastava, A.; Singh, A.P.; Singh, S.P.; Nath, G.; Srivastava, R.; Srivastava, B.S. Isolation and identification of a new antibacterial entity from the Antarctic cyanobacterium Nostoc CCC 537. Environ. Boil. Fishes 2008, 21, 81–88. [Google Scholar]
- Yang, L.; Quan, X.; Xue, B.; Goodwin, P.H.; Lu, S.; Wang, J.; Du, W.; Wu, C. Isolation and identification of Bacillus subtilis strain YB-05 and its antifungal substances showing antagonism against Gaeumannomyces graminis var. tritici. Boil. Control. 2015, 85, 52–58. [Google Scholar] [CrossRef]
- Bilal, M.; Rasheed, T.; Iqbal, H.M.; Hu, H.; Zhang, X. Silver Nanoparticles: Biosynthesis and Antimicrobial Potentialities. Int. J. Pharmacol. 2017, 13, 832–845. [Google Scholar] [CrossRef]
- Bilal, M.; Rasheed, T.; Iqbal, H.M.; Hu, H.; Wang, W.; Zhang, X. Macromolecular agents with antimicrobial potentialities: A drive to combat antimicrobial resistance. Int. J. Boil. Macromol. 2017, 103, 554–574. [Google Scholar] [CrossRef]
- Rasheed, T.; Bilal, M.; Iqbal, H.M.; Li, C. Green biosynthesis of silver nanoparticles using leaves extract of Artemisia vulgaris and their potential biomedical applications. Colloids Surfaces B Biointerfaces 2017, 158, 408–415. [Google Scholar] [CrossRef] [PubMed]
- Rasheed, T.; Bilal, M.; Li, C.; Iqbal, H.M. Biomedical Potentialities of Taraxacum officinale-based Nanoparticles Biosynthesized Using Methanolic Leaf Extract. Curr. Pharm. Biotechnol. 2017, 18, 1116–1123. [Google Scholar] [CrossRef] [PubMed]
- Tabbene, O.; Benslimen, I.; Djebali, K.; Mangoni, M.-L.; Urdaci, M.C.; Limam, F. Optimization of medium composition for the production of antimicrobial activity by Bacillus subtilis B38. Biotechnol. Prog. 2009, 25, 1267–1274. [Google Scholar] [CrossRef]
- Bais, H.P.; Fall, R.; Vivanco, J.M. Biocontrol of Bacillus subtilis against Infection of Arabidopsis Roots by Pseudomonas syringae Is Facilitated by Biofilm Formation and Surfactin Production1. Plant Physiol. 2004, 134, 307–319. [Google Scholar] [CrossRef]
- Caldeira, A.T.; Feio, S.; Arteiro, J.; Coelho, A.V.; Roseiro, J. Environmental dynamics of Bacillus amyloliquefaciens CCMI 1051 antifungal activity under different nitrogen patterns. J. Appl. Microbiol. 2008, 104, 808–816. [Google Scholar] [CrossRef] [PubMed]
- Wang, Q.-Y.; Lin, Q.; Peng, K.; Cao, J.-Z.; Yang, C.; Xu, N. Surfactin Variants from Bacillus subtilis natto CSUF5 and Their Antifungal Properities Against Aspergillus niger. J. Biobased Mater. Bioenergy 2017, 11, 210–215. [Google Scholar] [CrossRef]
- Wei, Y.; Wang, L.; Chang, J.-S. Optimizing Iron Supplement Strategies for Enhanced Surfactin Production with Bacillus subtilis. Biotechnol. Prog. 2004, 20, 979–983. [Google Scholar] [CrossRef]
- Yeh, M.-S.; Wei, Y.-H.; Chang, J.-S. Enhanced Production of Surfactin from Bacillussubtilis by Addition of Solid Carriers. Biotechnol. Prog. 2008, 21, 1329–1334. [Google Scholar] [CrossRef]
- Cooper, D.G.; Macdonald, C.R.; Duff, S.J.B.; Kosaric, N. Enhanced Production of Surfactin from Bacillus subtilis by Continuous Product Removal and Metal Cation Additions. Appl. Environ. Microbiol. 1981, 42, 408–412. [Google Scholar] [CrossRef] [PubMed]
- Das, P.; Mukherjee, S.; Sen, R. Genetic Regulations of the Biosynthesis of Microbial Surfactants: An Overview. Biotechnol. Genet. Eng. Rev. 2008, 25, 165–186. [Google Scholar] [CrossRef] [PubMed]
- Yakimov, M.M.; Timmis, K.N.; Wray, V.; Fredrickson, H.L. Characterization of a new lipopeptide surfactant produced by thermotolerant and halotolerant subsurface Bacillus licheniformis BAS50. Appl. Environ. Microbiol. 1995, 61, 1706–1713. [Google Scholar] [CrossRef] [PubMed]
- Hiradate, S.; Yoshida, S.; Sugie, H.; Yada, H.; Fujii, Y. Mulberry anthracnose antagonists (iturins) produced by Bacillus amyloliquefaciens RC-2. Phytochemistry 2002, 61, 693–698. [Google Scholar] [CrossRef]
- Sandrin, C.; Peypoux, F.; Michel, G. Coproduction of surfactin and iturin A, lipopeptides with surfactant and antifungal properties, by Bacillus subtilis. Biotechnol. Appl. Biochem. 1990, 12, 370–375. [Google Scholar]
- Vollenbroich, D.; Pauli, G.; Ozel, M.; Vater, J. Antimycoplasma properties and application on cell cultures of surfactin, a lipopeptide antibiotic from Bacillus subtilis. Appl. Environ. Microbiol. 1997, 63, 44–49. [Google Scholar] [CrossRef]
- Yu, G.; Sinclair, J.; Hartman, G.; Bertagnolli, B. Production of iturin A by Bacillus amyloliquefaciens suppressing Rhizoctonia solani. Soil Boil. Biochem. 2002, 34, 955–963. [Google Scholar] [CrossRef]
- Cho, S.-J.; Lee, S.K.; Cha, B.J.; Kim, Y.H.; Shin, K.-S. Detection and characterization of the Gloeosporium gloeosporioides growth inhibitory compound iturin A from Bacillus subtilis strain KS03. FEMS Microbiol. Lett. 2003, 223, 47–51. [Google Scholar] [CrossRef]
- Lim, J.-H.; Park, B.-K.; Kim, M.-S.; Hwang, M.-H.; Rhee, M.H.; Park, S.-C.; Yun, H.-I. The anti-thrombotic activity of surfactins. J. Veter Sci. 2005, 6, 353–355. [Google Scholar] [CrossRef]
© 2020 by the authors. Licensee MDPI, Basel, Switzerland. This article is an open access article distributed under the terms and conditions of the Creative Commons Attribution (CC BY) license (http://creativecommons.org/licenses/by/4.0/).